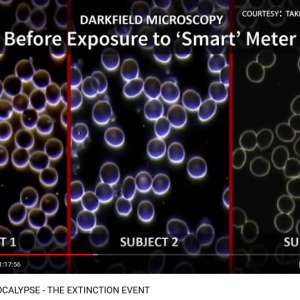
Image
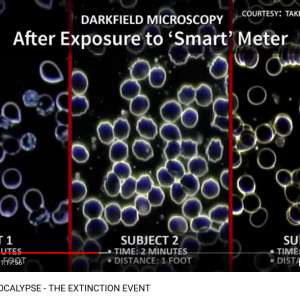
Image

Marian Kamp
@MarianKamp
13 January, 05:22
Corrupt gang
George/Alex Soros-many foundations
Rothschild-World bank families
Klaus Schwab-World Economic Forum(WEF)
World Health Organization(WHO)
CCP
Big pharma
Bill Gates
Larry Fink-BlackRock, State Street
Corrupt media
UN
NATO
MIC
CDC
George/Alex Soros-many foundations
Rothschild-World bank families
Klaus Schwab-World Economic Forum(WEF)
World Health Organization(WHO)
CCP
Big pharma
Bill Gates
Larry Fink-BlackRock, State Street
Corrupt media
UN
NATO
MIC
CDC
Notice: Undefined index: tg1tga_access in /home/admin/www/anonup.com/themes/default/apps/timeline/post.phtml on line 396
Once I wouldn't have recognised so many faces! Now I recognise almost all or them.
Great memes!
Sharing a few more. I forget I have some of these memes until I search.
If you don't already have a smart meter, don't give in to it! They damage your cells.
My electricity provider has been telling porkies, that the law requires a meter to be replaced after an expiry date. There is no such law!
I pulled them up on it, they tried it a second time which I ignored. I had asked them to point me to this law, they ignored that too. I would have to relocate the meter outside which would cost £3,000, they told me we could come to some arrangement! Ye sure, like charge me monthly, they don't do that job, the main producer does.
The gov. has given them targets and incentives to push it.
Great memes!
Sharing a few more. I forget I have some of these memes until I search.
If you don't already have a smart meter, don't give in to it! They damage your cells.
My electricity provider has been telling porkies, that the law requires a meter to be replaced after an expiry date. There is no such law!
I pulled them up on it, they tried it a second time which I ignored. I had asked them to point me to this law, they ignored that too. I would have to relocate the meter outside which would cost £3,000, they told me we could come to some arrangement! Ye sure, like charge me monthly, they don't do that job, the main producer does.
The gov. has given them targets and incentives to push it.
06:09 AM - Jan 13, 2025
In response Marian Kamp to her Publication
Only people mentioned by JRFREEDOMFIGHTER in this post can reply